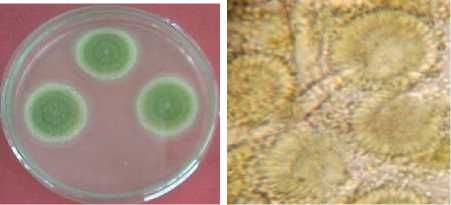

TOTAL BAKTERI PADA JAMU TRADISIONAL DI PASAR KEDONGANAN KELURAHAN JIMBARAN KABUPATEN BADUNG PROVINSI BALI
on
JURNAL BIOLOGI XVI (2) : 31 - 35
ISSN : 1410 5292
IDENTIFIKASI FUNGI DAN TOTAL BAKTERI PADA JAMU TRADISIONAL
DI PASAR KEDONGANAN KELURAHAN JIMBARAN KABUPATEN BADUNG PROVINSI BALI
IDENTIFICATION OF FUNGI AND TOTAL BACTERIA ON TRADITIONAL HERBAL MEDICINE AT KEDONGANAN MARKET OF JIMBARAN, BADUNG – BALI
Putu Ayu Sukmawati, Meitini W Proborini, Retno Kawuri Jurusan Biologi, Fakultas Matematika dan Ilmu Pengetahuan Alam, Kampus Bukit Jimbaran, Universitas Udayana ayu_sukma31@yahoo.co.id
INTISARI
Penelitian ini bertujuan untuk mengetahui jenis-jenis cendawan, total koloni bakteri, dan mengetahui keberadaan bakteri pencemar Escherichia coli yang terdapat pada jamu tradisional di Pasar Kedonganan. Sampel diambil dari 4 pedagang jamu, setiap pedagang diambil 4 sampel jamu yaitu jamu beras kencur, sirih, kunyit dan sambiloto. Perhitungan total koloni cendawan dan total koloni bakteri pada jamu dilakukan dengan menggunakan metode pengenceran dan total koloni bakteri secara statistik dianalisa dengan menggunakan Rancangan Acak Lengkap (RAL). Hasil penelitian menunjukkan ditemukan enam jenis cendawan yaitu Aspergillus niger, A. flavus, Penicillium citrinum, P. digitatum, P. brevicompactum, dan Acremonium sp pada jamu. Total jumlah koloni cendawan tertinggi ditemukan pada jamu beras kencur (107x105 CFU/ml) sedangkan terendah ditemukan pada jamu kunyit (20,5x105 CFU/ml). Batas standar kandungan jamur pada makanan yang direkomendasikan oleh Departemen Kesehatan RI adalah sebesar <104 CFU/ml. Total bakteri tertinggi ditemukan pada jamu beras kencur (267,6x108 CFU/ml), sedangkan terendah ditemukan pada jamu kunyit (39x108CFU/ml). Kandungan bakteri keseluruhan jamu yang diuji telah melampaui ambang batas Departemen Kesehatan RI yaitu sebesar <106 CFU/ml. E.coli ditemukan pada jamu sambiloto, jamu kunyit, jamu beras kencur, oleh karena itu kehati-hatian perlu dilakukan jika meminum jamu.
Kata kunci: jamu, cendawan, total bakteri, Escherichia coli
ABSTRACT
This aims of the study were to determine the types of fungi, total colony bacteria, and the present by Escherichia coli as a contaminant bacteria found in traditional juice (jamu) as herbal medicine at Kedonganan Market. Samples were taken from 4 juice treaders. Four different inggridient of juices (beras kencur/ rice and white tumeric), sirih/ Piper betel, kunyit/ turmeric and sambiloto/ Andrographis were taken from each seller. The total of fungal and bacterial colonies on those jamu were calculated. The data collected were statistically analysed using a Completely Randomized Design (CRD). The results showed that six types of fungi were found i.e. Aspergillus niger, A. flavus, Penicillium citrinum, P. digitatum, P. brevicompactum, and Acremonium sp. The highest number of fungal colonies were detected in beras kencur (107x105 CFU/ml), and the lowest were in kunyit (20,5x105 CFU/ml). The Ministry of Health of Indonesian government recommended fungal content in food was less than 104 CFU/ ml. The total bacteria colonies present in jamu was highest in beras kencur (267,6 x108 CFU/ml) and the lowest was in kunyit (39x108CFU/ml). The Indonesian government recommended bacteria in food should be less than 106 CFU/ml. It means that either the fungal or bacteria content in jamu was exceed the Indonesian Government recommendation. Esceria coli was detected in sambiloto, turmeric and beras kencur. Therefore, caution should be taken to consume jamu as a herbal medicine.
Keywords: herbs, fungi, total bacteria, Escherichia coli
PENDAHULUAN
Tanaman obat merupakan sumber daya alam hayati yang memiliki nilai ekonomi tinggi. Pemanfaatan obat tradisional pada umumnya lebih diutamakan untuk mencegah penyakit dan menjaga kesehatan, serta upaya sebagai pengobatan suatu penyakit (Santoso, 2000). Salah satu kelompok obat tradisional adalah jamu. Jamu sudah dikenal di Indonesia, khususnya di Pulau Jawa sebagai sarana perawatan kesehatan sehari-hari
maupun sebagai sarana pemulihan kesehatan dari sakit. Ramuan yang ada di dalam jamu terdiri dari berbagai bagian tanaman yang saling bekerja sama membantu perawatan dan untuk pencegahan penyakit. Hal ini juga dinyatakan oleh Soedibyo (2004) bahwa penggunaan jamu bermanfaat untuk menjaga kesehatan.
Secara umum jamu memiliki dua bentuk yaitu serbuk dan cair. Jamu serbuk merupakan jamu dalam kemasan yang siap diseduh dengan bahan alam yang telah diuji sanitasinya, bahan baku dan produk sudah distandarisasi
sedangkan jamu dalam bentuk cair biasa disebut jamu gendong, dijual penjaja untuk konsumen (Depkes,2000). Jamu dibuat dari bahan-bahan alami, berupa bagian dari tanaman seperti rimpang, daun-daunan, buah dan kulit batang. Proses pembuatan jamu dimulai dari pemilihan bahan baku, pencucian, pengolahan dan penyajian dengan cara yang masih sangat sederhana, sehingga tidak menutup kemungkinan apabila jamu-jamu tersebut tercemar oleh mikroorganisme. Menurut Suharmiati dan Handayani (1998), pencemaran mikroba pada produk-produk tradisional (termasuk jamu) dan produk makanan pada umumnya bersumber dari bahan baku, pekerja dan lingkungan pengolahan termasuk peralatan produksi.
Di Bali pada beberapa wilayah masih banyak ditemui penjual jamu gendong yang menjajakan dagangannya di dalam pasar (Pasar Kedonganan), jamu-jamu yang di jual di Pasar Kedonganan diminati masyarakat karena mereka sangat percaya bahwa jamu-jamu tradisional dapat membantu menyembuhkan penyakit, namun para pedagang jamu masih sangat tradisional dalam mengolah jamu sehingga diasumsikan kurang memperhatikan higienitas dan sanitasi, baik produk maupun lingkungan.
MATERI DAN METODE
Identifikasi Cendawan
Isolasi cendawan dilakukan dengan metode pengenceran. Sampel jamu gendong (beras kencur, sirih, kunyit dan sambiloto) masing-masing diambil 1 ml kemudian dicampur dengan 9 ml air steril sebagai pengenceran 10-1. Metode yang sama dilakukan untuk pengenceran 10-2-10-5. Masing-masing pengenceran diambil 1 ml dan dituang dalam cawan petri steril, diputar cawan petri hingga homogen, diinkubasi 2-3 hari pada suhu ruang dan hifa yang tumbuh dapat diamati dan dipindahkan ke media PDA, kemudian diidentifikasi (Proborini, 2002). Identifikasi cendawan dilakukan pengamatan secara makrokopis dan mikrokopis. Literatur yang digunakan untuk mengidentifikasi cendawan adalah Fungi and Food Spoilage (Pitt dan Hocking, 1997), Pengenalan Kapang Tropik Umum (Gandjar dkk., 1999) dan Pengantar Mikologi (Darnetty, 2006).
Perhitungan Jumlah Total Bakteri
Perhitungan total bakteri dilakukan dengan Metode Pengenceran/ Platting Method (Pelczar dan Chan, 2006) yaitu dengan mengambil sampel jamu dari masing-masing sampel yang berbeda dan diambil sebanyak 10 ml kemudian sampel dimasukkan ke dalam botol yang telah berisi air steril sebanyak 90 ml sehingga didapatkan pangkat pengenceran 10-1 dan dilakukan berseri hingga 10-8. Sampel ditanam dengan cara diambil 1 ml dan diletakkan pada cawan petri steril yang kemudian ditambahkan media NA pada suhu 400C, dihomogenkan dan diinkubasi dalam keadaan terbalik pada suhu 370C selama 24 jam (Kawuri dkk, 2007). Untuk perhitungan dilakukan dengan menghitung jumlah koloni setiap cawan petri antara 25-250, jika tidak ada yang memenuhi syarat maka dipilih yang jumlahnya mendekati 25 atau 250 (Pelczar dan Chan, 2006).
Uji Keberadaan Bakteri E.coli
Seluruh sampel jamu diuji keberadaan bakteri E.coli dengan cara sampel diambil 1 ose dan digoreskan pada media selektif EMBA kemudian diinkubasi pada suhu 37oC selama 24-48 jam. Hasil positif ditandai dengan koloni E.coli berwarna hijau metalik (Kawuri dkk., 2007). Hasil total koloni bakteri dan cendawan dianalisa statistik dengan menggunakan Rancangan Acak Lengkap (RAL) dengan parameter jenis jamu (4) dan pedagang (4), kemudian dianalisis dengan ANOVA jika diperoleh hasil yang berbeda nyata pada p<0,05 maka dilanjutkan dengan menggunakan uji Duncan.
HASIL
Isolasi Cendawan
Berdasarkan hasil pengamatan didapatkan koloni cendawan yang tumbuh pada media PDA dan hasil identifikasi secara makroskopis maupun mikroskopis ditemukan enam spesies cendawan yaitu Aspergillus niger, A. flavus, Penicillium citrinum, P.digitatum, P.brevicompactum, dan Acremonium sp.

Gambar 1. Aspergillus niger
Secara makroskopis cendawan ini memiliki koloni berwarna hitam dengan warna sebalik koloni abu-abu, membentuk garis-garis radier. Secara mikroskopis cendawan ini hifa berseptat, membentuk vesikel, terdapat sterigma, konidia berbentuk bulat seperti bola berukuran 3,5µm (Pitt dan Hocking, 1997).
Gambar 2. Aspergillus flavus
Koloni secara makroskopis berwarna hijau kekuningan dengan warna sebalik koloni berwarna kuning keabuan. Secara mikroskopis konidia khas berbentuk bulat, berukuran 2,5 µm, konidiofor kasar, fialid terbentuk langsung pada vesikula atau pada metula (Gandjar, 1999).

Gambar 3. Penicillium citrinum
Secara makroskopis koloni ini berwarna kuning hingga jingga. Sedangkan secara mikroskopis konidifor berdinding halus terdapat fialid berbentuk seperti botol. Konidia berbentuk bulat-semibulat, berdinding halus sebagian dinding kasar (bergranula) dan berdiameter 3 µm (Gandjar, 1999).

Gambar 4. Penicillium digitatum
Secara makroskopis permukaan koloni seperti beludru dan berwarna kuning dengan sebalik koloni berwana kuning muda. Sedangkan secara mikroskopis konidiofor bercabang tidak teratur, fialid berbentuk silindris dengan leher yang pendek, konidia berbentuk elips hingga silindris, berukuran 3,5 µm (Gandjar, 1999).

Gambar 5. Penicillium brevicompactum
Koloni secara makroskopis berwarna hijau tua dengan warna sebalik koloni berwarna hijau muda kekuningan. Secara mikroskopis fialid berbentuk seperti botol, konidia bulat, berukuran 1,5 µm dan konidifor berdinding halus (Pitt dan Hocking, 1997).

Gambar 6. Acremonium sp
Koloni secara makroskopis koloni seperti beludru berwarna putih keabuan dengan sebalik koloni berwarna coklat tua dan terdapat garis-garis lateral. Secara mikroskopis konidia berbentuk elips berukuran 3,2 µm berdinding halus, dan konidiofor bercabang (Gandjar, 1999).
Tabel 1. Total Koloni Cendawan pada Jenis Jamu di Pasar Kedonganan
Rata-rata total cendawan pada berbagai jenis jamu (CFU/ml)
|
Pedagang |
A (beras kencur) |
B (kunyit) |
C (sirih) |
D (sambiloto) |
|
1. |
76x105 |
39x105 |
110x105 |
76x105 |
|
2. |
107x105 |
20,5x105 |
27x105 |
87x105 |
|
3. |
101,5x105 |
25x105 |
67x105 |
89,5x105 |
|
4. |
95x105 |
46x105 |
47,3x105 |
83,5x105 |
Tabel 2. Total koloni bakteri pada jenis jamu yang beredar di Pasar Kedon-ganan
|
No. |
Jenis jamu |
Rata-rata total bakteri CFU/ml |
|
1. |
Beras kencur |
121,4(c) |
|
2. |
Kunyit |
49,00(a) |
|
3. |
Sirih |
66,66(ab) |
|
4. |
Sambiloto |
75,66(a) |
Keterangan:
Uji Anova (α=0,05) dilanjutkan dengan Uji Duncan taraf 5%. Huruf sama pada kolom yang sama menunjukkan tidak adanya perbedaan yang nyata.
Tabel 3. Total koloni bakteri pada jenis jamu berdasarkan pedagang yang beredar di Pasar Kedonganan
|
No. |
Pedagang |
Rata-rata total bakteri CFU/ml |
|
1. |
1 |
125,83(b) |
|
2. |
2 |
56,58(a) |
|
3. |
3 |
58,16(a) |
|
4. |
4 |
72,16(a) |
Keterangan:
Uji Anova (α=0,05) dilanjutkan dengan Uji Duncan taraf 5%. Huruf sama pada kolom yang sama menunjukkan tidak adanya perbedaan yang nyata.
Tabel 4. Uji keberadaan bakteri pencemar E.coli pada jamu gendong (beras kencur, kunyit, sirih, dan sambiloto) di Pasar Kedonganan
|
No. |
Pedagang |
Jenis Jamu |
Keberadaan E.coli |
|
1. |
1 |
Beras Kencur |
- |
|
2. |
Kunyit |
- | |
|
3. |
Sirih |
- | |
|
4. |
Sambiloto |
+ | |
|
5. |
2 |
Beras Kencur |
+ |
|
6. |
Kunyit |
- | |
|
7. |
Sirih |
- | |
|
8. |
Sambiloto |
- | |
|
9. |
3 |
Beras Kencur |
- |
|
10. |
Kunyit |
- | |
|
11. |
Sirih |
- | |
|
12. |
Sambiloto |
- | |
|
13. |
4 |
Beras Kencur |
+ |
|
14. |
Kunyit |
- | |
|
15. |
Sirih |
- | |
|
16. |
Sambiloto |
- |
Hasil pengamatan uji keberadaan E.coli ditemukan adanya bakteri yang berwarna hijau mengkilat menunjukan adanya bakteri E.coli, dapat terlihat pada gambar berikut:

Gambar 7. Foto Koloni E.coli Berwarna Hijau Metalik pada Media EMBA
PEMBAHASAN
Pada Tabel 1 menunjukkan total koloni cendawan tertinggi terdapat pada jamu beras kencur yaitu sebesar 110 x105 CFU/ml . Hal ini disebabkan bahan baku dalam pembuatan beras kencur yang terdiri dari beras, kencur dan gula. Menurut Fardiaz (1992) beras mengandung karhohidrat dan glukosa yang merupakan tempat cendawan untuk memperoleh energi. Selain itu, keberadaan cendawan dan bakteri dapat disebabkan bahan baku yang digunakan sudah terkontaminasi mikroba, dimana pada proses pembuatan jamu-jamu tersebut para pedagang kurang memperhatikan kebersihan baik selama proses pembuatan atau bahkan lingkungan tempat para pedagang tersebut berjualan.
Pertumbuhan total koloni cendawan terendah terdapat pada jamu kunyit yaitu sebesar 20,5x105 CFU/ ml, hal ini dikarenakan kunyit mengandung senyawa metabolit sekunder atau zat antimikroba. Griffin (1981) menyatakan bahwa kurkumin adalah senyawa antifungi yang terkandung di dalam ekstrak kunyit yang merupakan bagian dari komponen minyak atsiri kunyit yang mengandung senyawa metabolit sekunder yang termasuk ke dalam golongan seskuiterpen. Menurut Departemen Kesehatan RI, seluruh sampel dari produsen jamu tradisional tersebut menunjukkan jumlah angka kontaminasi cendawan melebihi standar batas kontaminasi cendawan yang masih dianggap aman untuk dikonsumsi pada obat tradisional sesuai yang disyaratkan yaitu sebesar <104 CFU/ml.
Pedagang 3 memiliki jumlah cendawan yang tertinggi, dari hasil survey pada pedagang jamu 3 proses pengolahan jamu sangat tidak higienis sehingga tidak menutup kemungkinan terjadi kontaminasi oleh spora-spora mikroba saat proses pengolahan. Selain itu pengaruh faktor lokasi penjualan juga sangat mendukung terjadinya kontaminasi mikroba yang terdapat di udara pasar. Sedangkan, pada sampel jamu pedagang 2 memiliki pertumbuhan cendawan terendah. Hal ini dikarenakan faktor lingkungan di sekitar tempat berjualan yang higienis. Hal ini didukung dengan pendapat Pratiwi (2012) bahwa besarnya jumlah koloni cendawan dalam sediaan jamu tersebut dapat disebabkan pada saat pengangkutan dan pemasaran, karena kemasan tidak disegel, mudah dibuka dan dapat berhubungan dengan udara luar.
Cendawan yang paling banyak ditemukan dari keempat sampel jamu (beras kencur, kunyit, sirih dan sambiloto) adalah A.niger dan A. flavus sedangkan Acremonium sp pertumbuhan lebih sedikit. Kedua cendawan ini dapat
tumbuh lebih banyak ditemukan dikarenakan cendawan ini mampu berkompetisi dengan cendawan yang lain dan dapat mengeluarkan metabolit sekunder yang bisa menghambat pertumbuhan cendawan lainnya, sehingga cendawan ini dapat mengabsorbsi nutrisi yang lebih banyak dan menyebabkan pertumbuhannya lebih cepat. Faktor lingkungan yang dapat mendukung kecepatan pertumbuhan cendawan yaitu suhu, kelembaban dan intensitas cahaya (Syarief dkk, 2003).
Berdasarkan data pada Tabel 3 diperoleh rata-rata total koloni bakteri yang ditemukan pada jenis jamu yaitu beras kencur, kunyit, sirih dan sambiloto. Pada jamu beras kencur mengandung total koloni tertinggi (121,4 CFU/ml) berbeda nyata (P<0,05) dibandingkan dengan jenis jamu kunyit, sirih, dan sambiloto. Kandungan total koloni bakteri pada jamu kunyit dan sambiloto tidak berbeda nyata (P>0,05) sedangkan jamu sirih memiliki total koloni bakteri yang berbeda nyata (P<0,05) dengan kunyit dan sambiloto. Pada tabel 4 menunjukkan total koloni bakteri tertinggi (125,83 CFU/ml) terdapat pada pedagang 1 yang berbeda nyata (P<0,05) dengan pedagang lainnya (pedagang 2, 3 dan 4).
Total bakteri tertinggi terdapat pada jamu beras kencur yaitu sebesar 267,6 x 108 CFU/ml. Hal ini kemungkinan disebabkan karena air yang digunakan untuk membuat jamu tidak dimasak hingga mendidih, bahan baku yang tidak bersih dan proses pembuatan yang tidak higienis. Sedangkan total bakteri terendah terdapat pada jamu kunyit pada yaitu sebesar 39x108 CFU/ml karena kunyit memiliki senyawa kurkumin. Menurut Madigan (2005), senyawa kurkumin dapat menghambat pertumbuhan mikroba dengan cara merusak membran sel sehingga menyebabkan denaturasi protein sel yang akan mengubah permeabilitas membran dan menyebabkan kebocoran nutrisi pada sel bakteri sehingga sel tersebut mati. Dari keempat pedagang jamu total bakteri tertinggi terdapat pada pedagang 1. Dari hasil pengamatan pedagang 1 di lingkungan tempat berjualan jamu yang tidak higienis dan rendahnya sanitasi, sehingga tidak menutup kemungkinan terjadi kontaminasi spora-spora bakteri saat penuangan jamu. Menurut Sayuti dkk (2005), pengaruh faktor lokasi penjualan jamu gendong dan beberapa penjual jamu tradisional menjual jamu di area yang tidak higienis yang memungkinkan banyak terjadinya kontaminasi jamu dari mikroba udara. Sedangkan total bakteri terendah terdapat pada pedagang 2, hal ini disebabkan karena pedagang 2 berjualan di tempat yang lebih bersih bila dibandingkan dengan lokasi pedagang lainnya dan berdasarkan dari hasil wawancara dimana pedagang tersebut, pada waktu mengolah jamu dengan cara merebus kembali ekstrak hingga mendidih. Dari data tersebut didapatkan bahwa populasi bakteri pada seluruh jamu yang diuji telah melampaui ambang batas yang diperbolehkan oleh Departemen Kesehatan RI yaitu sebesar <106 CFU/ml.
Uji keberadaan bakteri E.coli jamu gendong dengan menggunakan media EMBA diperoleh hasil positif mengandung E.coli pada pedagang 1 jamu sambiloto, pedagang 2 jamu beras kencur, pedagang 4 jamu beras kencur seperti yang terlihat pada Tabel 5. Hal ini
disebabkan air yang digunakan dalam pembuatan jamu berasal dari air yang tidak dimasak sampai mendidih sehingga spora dari bakteri E.coli dapat tumbuh, dan alat dan bahan yang digunakan tidak dicuci bersih, meskipun dari hasil wawancara didapatkan hasil bahwa air dimasak terlebih dahulu. Pertumbuhan dan perkembangan bakteri dipengaruhi oleh zat makanan (nutrisi), keasaman (pH), temperatur, oksigen, tekanan osmosa, dan kelembaban (Dwijosaputro, 1985). Menurut Rao (1994), jumlah bakteri setelah inkubasi selama 24 jam, jumlah akan terus bertambah jika masa inkubasi bakteri tersebut ditambah sampai batas tertentu tetapi populasi bakteri akan menurun hingga akhirnya mati seiring dengan zat gizi yang terdapat di dalam media habis.
Penyebab adanya bakteri E.coli pada sampel jamu tradisional diduga disebabkan oleh lingkungan tempat pembuatan jamu yang tidak higienis dan rendahnya sanitasi. Rahmawati et al (1988), menyatakan bahwa sanitasi berperan penting dalam pengolahan dan penjualan jamu. Dengan peningkatan sanitasi lingkungan dan tempat serta alat-alat produksi yang lebih baik serta mengacu pada standar produksi obat yang baik, merupakan suatu alternatif guna peningkatan mutu jamu. Berdasarkan hasil pengamatan di sekitar lokasi penjualan, lingkungan di sekitar sangat kotor dan dekat dengan tempat pemasaran ikan. Menurut Handayani dan Suharmiati (2000), sistem pengolahan dan penyajian yang kurang baik atau kurang higienis menyebabkan pencemaran mikroba pada jamu gendong. Jawetz (2001) menyatakan bahwa pencemaran oleh Escherichia coli akan mengganggu kesehatan konsumen dan penyakit yang ditimbulkan antara lain infeksi saluran kencing, septis, meningitis dan diare.
SIMPULAN
Ditemukan enam jenis cendawan pada sampel jamu tradisional yaitu A. niger, A. flavus, P.citrinum, P. digitatum, P. brevicompactum, dan Acremonium sp. Total jumlah cendawan terendah pada jamu kunyit pedagang 2 sebesar 20,5x105 CFU/ml sedangkan total jumlah cendawan tertinggi pada jamu beras kencur pedagang 3 sebesar 107x105 CFU/ml. Total bakteri tertinggi terdapat pada jamu beras kencur yaitu sebesar 267,6x108 CFU/ml dari pedagang 1 sedangkan total bakteri terendah terdapat pada jamu kunyit yaitu 39x108 CFU/ml dari pedagang 2. Terdapat bakteri E.coli pada tiga pedagang jamu di Pasar Kedonganan yaitu pada pedagang I (jamu sambiloto), pedagang II (jamu beras kencur), pedagang IV (jamu beras kencur).
KEPUSTAKAAN
Darnetty. 2006. Pengantar Mikologi. Andalas University Press: Padang.
Departemen Kesehatan RI, Direktorat Pengawasan Obat dan Makanan. 2000. Acuan Sediaan Herbal, DepKes RI, Jakarta.
Dwidjoseputro, D. 1994. Dasar-Dasar Mikrobiologi. Djambatan, Jakarta.
Fardiaz, S. 1992. Mikrobiologi Pangan 1. Penerbit PT. Gramedia Pustaka Utama. Jakarta.
Gandjar, I., R. A. Samson, K. T. Vermeulen, A. Oetari. I. Santoso. 1999. Pengenalan Kapang Tropik Umum. Yayasan Obor Indonesia. Jakarta.
Griffin, H.D. (1981). Fungal Physiology. New York. John Wiley & Sons, Inc.
Kawuri, R., Y. Ramona., I.B.G. Darmayasa. 2007. Penuntun Praktikum Mikrobiologi Umum Untuk Prodi Farmasi FMIPA UNUD. Laboratorium Mikrobiologi Jurusan Biologi FMIPA Universitas Udayana. Denpasar.
Madigan M. 2005. Brock Biology of Microorganisms. London: Prentice-Hall
Pelczar, M. J., Chan. Penerjemah R.S. Hadioetomo., T. Imas., S.S. Tjitrosomo. 2006. Dasar-Dasar Mikrobiologi. UI Press. Jakarta.
Pitt, J. I., A. D. Hocking. 1997. Fungi And Food Spoilage. Blackie Academic and Pofessional. Sydney.
Pratiwi, S.T. 2012. Pengujian Cemaran Bakteri dan Cemaran Kapang/ Khamir pada Produk Jamu Gendong di Daerah Istimewa Yogyakarta, Yogyakarta: Universitas Gadjah Mada.
Proborini, M. W. 2002. Penuntun Praktikum Mikologi. Laboratorium Taksonomi Tumbuhan Dan Mikologi. Jurusan Biologi Fakultas Matematika Universitas Udayana. Bukit Jimbaran.
Rahmawati, RA, Asih dan Supriyana. 1988. Selayang Pandang Jamu Gendong. Medika Jurnal Kedokteran dan Farmasi. Jakarta.
Rao, S. 1994. Mikroorganisme Tanah dan Pertumbuhan Tanaman. Universitas Indonesia UI-Press. Jakarta.
Santoso, S.S., 2000, Penelitian Manfaat Pengobatan Tradisional untuk Penyembuhan Penyakit Tidak Menular. JKPKBPPK/ Badan Litbang Kesehatan Departemen Kesehatan dan Kesejahteraan Sosial http://digilib.litbang.depkes.go.id Diakses: 19 April 2005
Sayuti, I., S. Wulandari., S. Fatimah. 2005. Bakteri Enterik dalam Minuman Jamu Gendong di Kota Pekanbaru. Jurnal Biogenesis Vol 2 (1). Universitas Riau.
Soedibyo, M. 2004. Jamu, Obat Sepanjang Zaman http://www. tokohindonesia.com/ensiklo–pedi/m/mooryat soedibyo/ opini.shtml Diakses: 18 April 2005
Suharmiati, L. Handayani. 1998, Bahan Baku, Khasiat dan Cara Pengolahan Jamu Gendong: Studi Kasus di Kotamadya Surabaya, Pusat Penelitian dan Pengembangan Pelayanan kesehatan, Departemen Kesehatan RI
http://www.tempo.co.id/medika/arsip/052001/art-1.htm Diakses: 18 April 2005
Syarief, R., L.Ega, C.C. Nurwitri. 2003. Mikotoksin Bahan Pangan. Institut Pertanian Bogor Press. Bogor.
35
Discussion and feedback